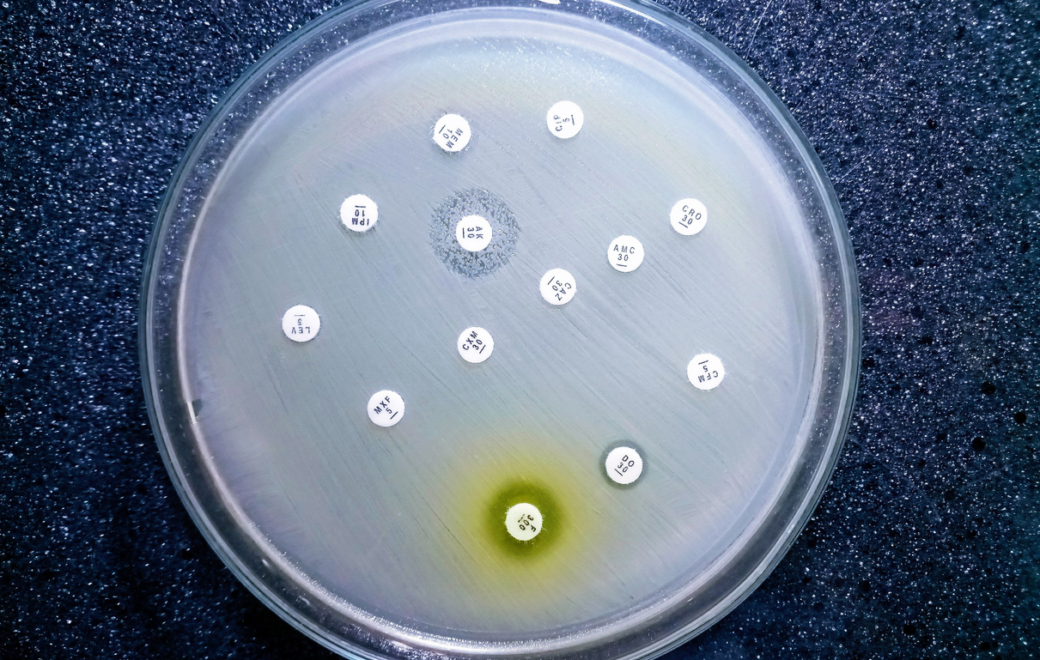
L’OMS alerte sur une résistance mondiale croissante aux antibiotiques

- Accueil ›
- Thérapeutique ›
- Vigilances ›
- L’OMS alerte sur une résistance mondiale croissante aux antibiotiques
© Getty Images
L’OMS alerte sur une résistance mondiale croissante aux antibiotiques
Selon le dernier rapport de l’Organisation mondiale de la Santé (OMS), près d’une infection bactérienne sur six est désormais résistante à un antibiotique courant. Cette tendance mondiale fragilise la prise en charge des infections courantes et menace l’efficacité des traitements.
Publié le 13 octobre 2025, le rapport du Global Antimicrobial Resistance and Use Surveillance System (GLASS) de l’OMS met en évidence une progression continue de l’antibiorésistance à l’échelle mondiale. En 2023, une infection bactérienne sur six confirmée en laboratoire s’est révélée résistante à un antibiotique de première intention. Les principales espèces concernées sont Escherichia coli, Klebsiella pneumoniae et Staphylococcus aureus, responsables d’infections urinaires, pulmonaires ou cutanées.
Une menace mondiale de santé publique
Plus de 40 % des couples bactérie-antibiotique suivis entre 2018 et 2023 présentent une hausse des résistances. L’OMS souligne la menace particulière des bactéries à Gram négatif, telles que E. coli et K. pneumoniae, capables d’échanger rapidement des gènes de résistance et souvent impliquées dans des infections sévères.
Les pays à revenu faible et intermédiaire sont les plus exposés, en raison d’un accès inégal aux antibiotiques et d’un usage non régulé. Selon le Dr Tedros Adhanom Ghebreyesus, directeur général de l’OMS, « la résistance aux antimicrobiens va plus vite que les progrès de la médecine moderne et menace la santé des familles dans le monde entier ». L’Organisation appelle à renforcer la surveillance, la régulation de la prescription et la recherche de nouvelles molécules.
Une tendance également observée en France
Les données de la mission Primo 2023 de Santé publique France, publiée en avril 2025, confirment cette évolution. En soins de ville, 3,8 % des souches d’E.coli isolées dans les infections urinaires étaient résistantes aux céphalosporines de 3ᵉ génération et 13,5 % aux fluoroquinolones.
Vers un renforcement de la surveillance internationale
Pour l’OMS, la lutte contre l’antibiorésistance nécessite une approche coordonnée : surveillance intégrée des usages, harmonisation des données et meilleur accès aux tests de diagnostic. L’Organisation encourage les États à intensifier les campagnes de sensibilisation auprès des professionnels de santé et du public, afin de préserver l’efficacité des antibiotiques disponibles et d’éviter que des infections bénignes ne puissent redevenir mortelles.
- Comptoir officinal : optimiser l’espace sans sacrifier la relation patient
- Reishi, shiitaké, maitaké : la poussée des champignons médicinaux
- Budget de la sécu 2026 : quelles mesures concernent les pharmaciens ?
- Cancers féminins : des voies de traitements prometteuses
- Vitamine A Blache 15 000 UI/g : un remplaçant pour Vitamine A Dulcis



